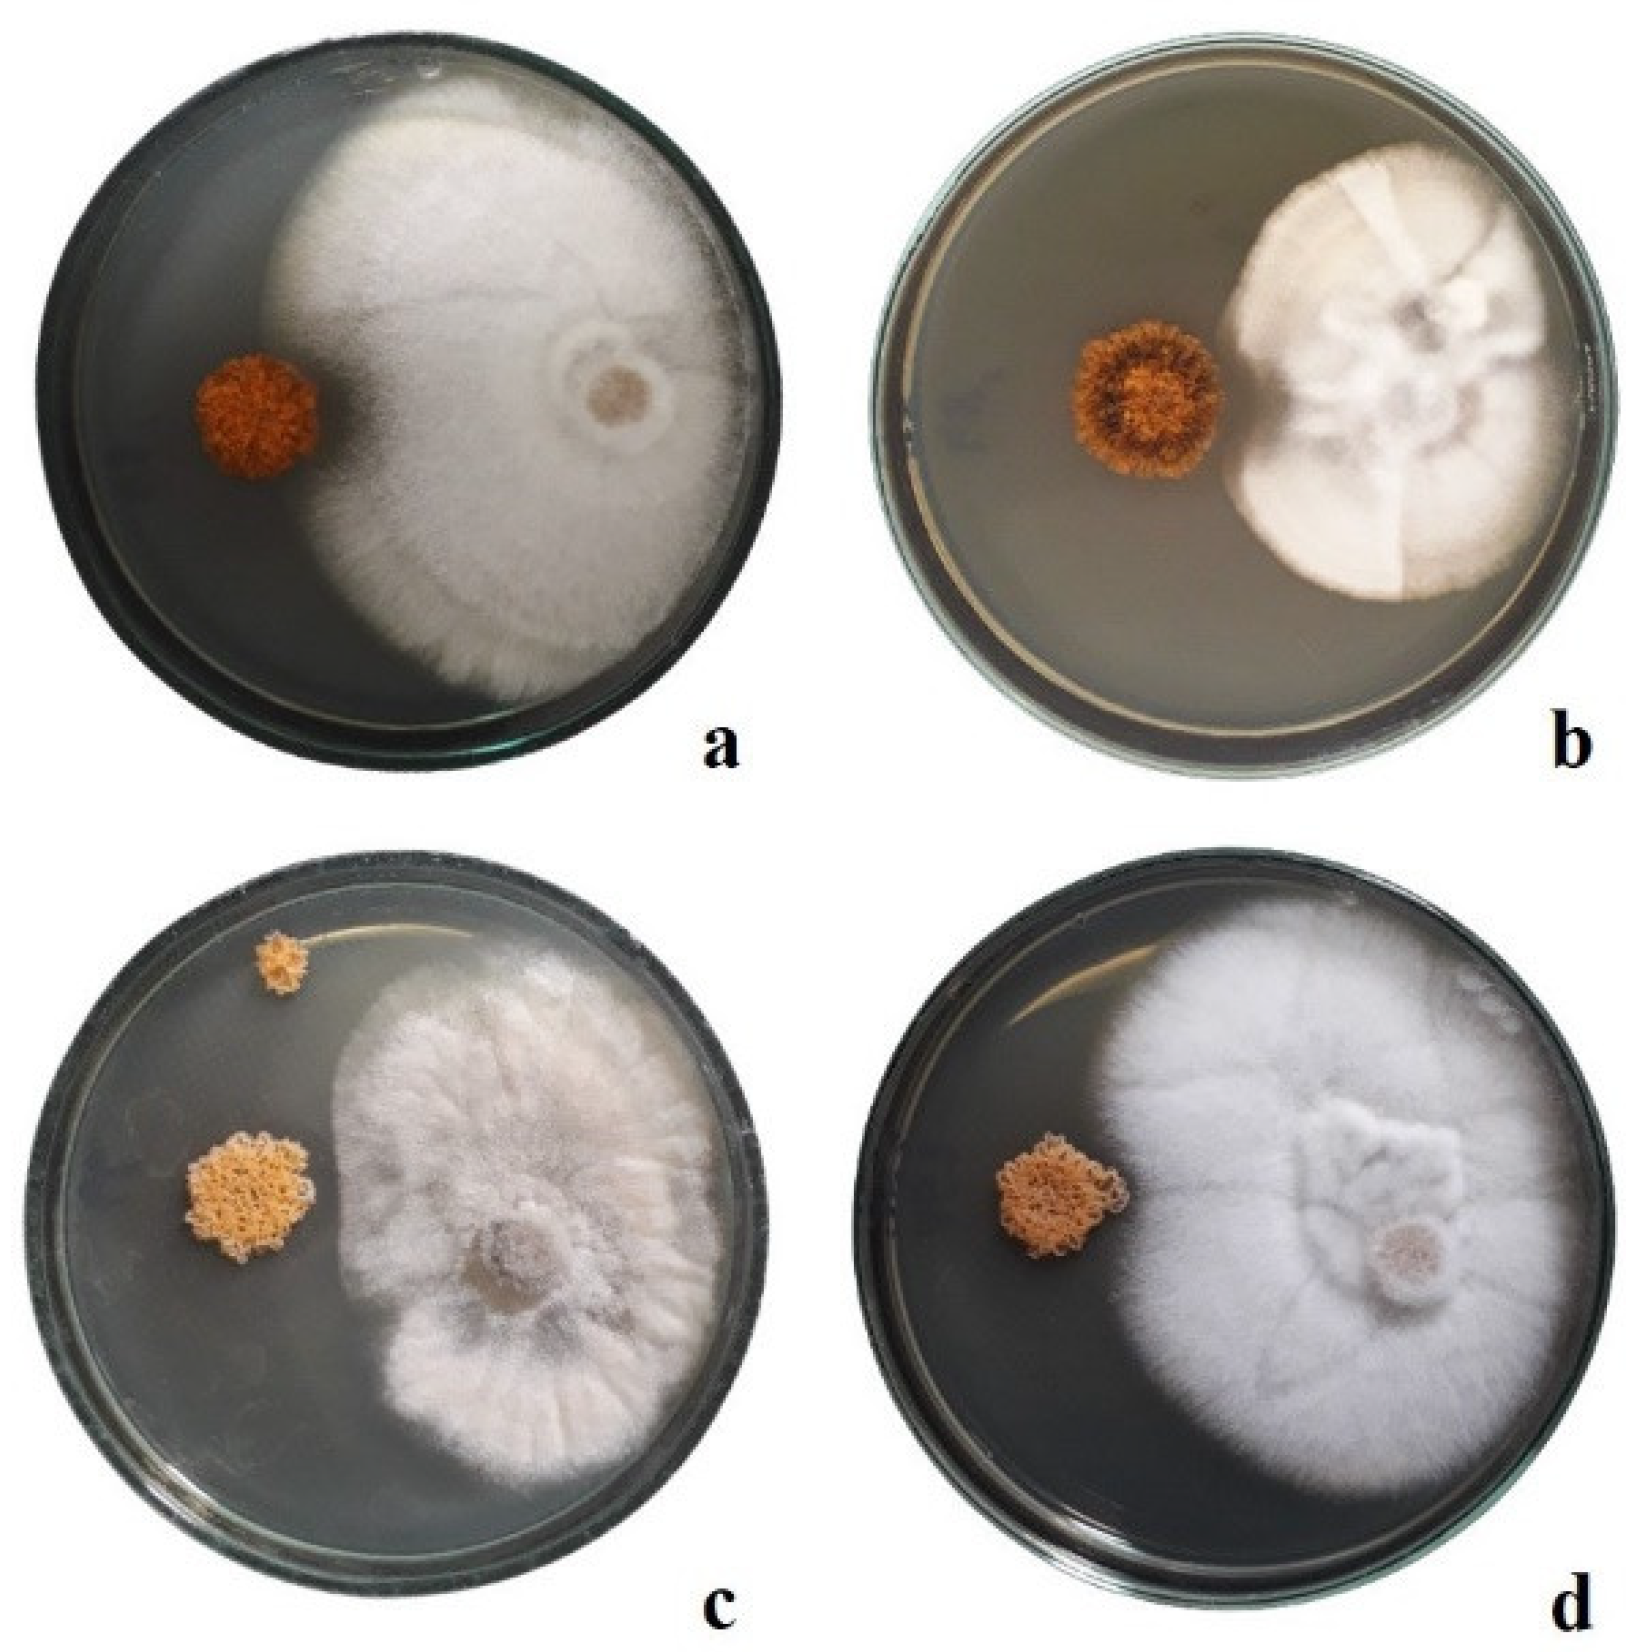

In Vitro Screening of Endophytic Micromonospora Strains Associated with White Clover for Antimicrobial Activity against Phytopathogenic Fungi and Promotion of Plant Growth
Abstract
1. Introduction
2. Materials and Methods
2.1. Plant Material and Isolation of Micromonospora Strains
2.2. Genomic DNA Extraction
2.3. Amplification of 16S rRNA Gene and Housekeeping Genes
2.4. Phylogenetic Analysis of Sequencing Data
2.5. Evaluation of Antifungal Properties
2.6. Agar Plug Diffusion Assay
2.7. Dual Culture Plate Assay
2.8. Production of Metallophores and Indole-3-Acetic Acid
3. Results and Discussion
3.1. Isolation of Micromonospora Strains and Genomic DNA Extraction
3.2. Phylogenetic Analysis of 16S rRNA Gene Sequences
3.3. Multilocus Sequence Analysis (MLSA) of Housekeeping Genes
3.4. Antifungal Properties
3.5. Production of Metallophores
3.6. Production of Indole-3-Acetic Acid
4. Conclusions
Supplementary Materials
Author Contributions
Funding
Data Availability Statement
Conflicts of Interest
References
- Trujillo, M.E.; Fernández-Molinero, C.; Velázquez, E.; Kroppensted, R.M.; Schumann, P.; Mateos, P.F.; Martínez-Molina, E. Micromonospora mirobrigensis sp. nov. Int. J. Syst. Evol. Microbiol. 2005, 55, 877–880. [Google Scholar] [CrossRef] [PubMed]
- Kuncharoen, N.; Kudo, T.; Ohkuma, M.; Tanasupawat, S. Micromonospora azadirachtae sp. nov., isolated from roots of Azadirachta indica A. Juss. var. siamensis Valeton. Antonie Van Leeuwenhoek 2019, 112, 253–262. [Google Scholar] [CrossRef] [PubMed]
- Kara Ali, M.; Ait Kaki, A.; Wahiba, K.; Bramki, A.; Benchabbi, A.; Kacem Chaouche, N. First study of Micromonospora echinospora isolation from a rocky site of Eastern Algeria and first report of its potential use in cementitious materials biohealing. S. Asian J. Exp. Biol. 2022, 12, 800–810. [Google Scholar] [CrossRef]
- Zhao, H.; Kassama, Y.; Young, M.; Kell, D.; Goodacre, R. Differentiation of Micromonospora isolates from a coastal sediment in Wales on the basis of fourier transform infrared spectroscopy, 16S rRNA sequence analysis, and the amplified fragment length polymorphism technique. Appl. Environ. Microbiol. 2004, 70, 6619–6627. [Google Scholar] [CrossRef] [PubMed][Green Version]
- Hirsch, A.M.; Valdés, M. Micromonospora: An important microbe for biomedicine and potentially for biocontrol and biofuels. Soil Biol. Biochem. 2010, 42, 536–542. [Google Scholar] [CrossRef]
- Ran, Y.; Zhang, Y.; Wang, X.; Li, G. Nematicidal metabolites from the actinomycete Micromonospora sp. WH06. Microorganisms 2022, 10, 2274. [Google Scholar] [CrossRef] [PubMed]
- Kumas, A.; Ertekin, S.G.; Gurbanov, R.; Şimşek, Y.E.; Kocak, F.O.; Değirmenci, L. Effect of Micromonospora sp. KSC08 on nitrogen conservation throughout composting. Biomass Convers. 2023, 13, 2375–2390. [Google Scholar] [CrossRef]
- Chen, S.J.; Lam, M.Q.; Thevarajoo, S.; Abd Manan, F.; Yahya, A.; Chong, S.C. Genome analysis of cellulose and hemicellulose degrading Micromonospora sp. CP22. 3 Biotech 2020, 10, 160. [Google Scholar] [CrossRef]
- Pavitra, R.; Raja, A. Optimization of conditions (influence of shaking, static and pH) for biodecolourization of reactive azo-based textile dye by Micromonospora sp. Appl. Ecol. Environ. Sci. 2020, 8, 282–286. [Google Scholar]
- Schneider, B.; Pfeiffer, F.; Dyall-Smith, M.; Kunte, H. Genome sequence of Micromonospora aurantiaca strain G9, a member of a bacterial consortium capable of polyethylene degradation. Microbiol. Resour. Announc. 2022, 11, e01148-21. [Google Scholar] [CrossRef]
- Carro, L.; Pujic, P.; Trujillo, M.E.; Normand, P. Micromonospora is a normal occupant of actinorhizal nodules. J. Biosci. 2013, 38, 685–693. [Google Scholar] [CrossRef]
- Prashith Kekuda, T.R.; Shobha, K.S.; Onkarappa, R. Fascinating diversity and potent biological activities of actinomycete metabolites. J. Pharm. Res. 2010, 3, 250–256. [Google Scholar]
- Ay, H.; Nouioui, N.; Klenk, H.P.; Cetin, D.; Igual, J.M.; Sahin, N.; Isik, K. Genome-based classification of Micromonospora craterilacus sp. nov., a novel actinobacterium isolated from Nemrut Lake. Antonie Van Leeuwenhoek 2020, 113, 791–801. [Google Scholar] [CrossRef] [PubMed]
- Riesco, R.; Ortúzar, M.; Fernández-Ábalos, J.M.; Trujillo, M.E. Deciphering genomes: Genetic signatures of plant-associated Micromonospora. Front. Plant Sci. 2022, 13, 872356. [Google Scholar] [CrossRef] [PubMed]
- Vincent, J.M. A Manual for the Practical Study of Root-Nodule Bacteria; Blackwell Scientific Publishers: Oxford, UK, 1970. [Google Scholar]
- Shirling, E.B.; Gottlieb, D. Methods for characterization of Streptomyces species. Int. J. Syst. Bacteriol. 1966, 16, 313–340. [Google Scholar] [CrossRef]
- Pitcher, D.G.; Saunders, N.A.; Owen, R.J. Rapid extraction of bacterial genomic DNA with guanidium thiocyanate. Lett. Appl. Microbiol. 1989, 8, 151–156. [Google Scholar] [CrossRef]
- Parker, M.A. Relationships of bradyrhizobia from the legumes Apios americana and Desmodium glutinosum. Appl. Environ. Microbiol. 1999, 65, 4914–4920. [Google Scholar] [CrossRef]
- Carro, L. Avances en la sistemática del género Micromonospora: Estudio de cepas aisladas de la rizosfera y nódulos de Pisum sativum. Ph.D. Thesis, University of Salamanca, Salamanca, Spain, 2011. [Google Scholar]
- Altschul, S.F.; Gish, W.; Miller, W.; Myers, E.W.; Lipman, D.J. Basic local alignment search tool. J. Mol. Biol. 1990, 215, 403–410. [Google Scholar] [CrossRef]
- Kumar, S.; Stecher, G.; Tamura, K. MEGA7: Molecular Evolutionary Genetics Analysis version 7.0 for bigger datasets. Mol. Biol. Evol. 2016, 33, 1870–1874. [Google Scholar] [CrossRef]
- Balouiri, M.; Sadiki, M.; Ibnsouda Koraichi, S. Methods for in vitro evaluating antimicrobial activity: A review. J. Pharm. Anal. 2016, 6, 71–79. [Google Scholar] [CrossRef]
- Hopwood, D.A. Genetic analysis and genome structure in Streptomyces coelicolor. Bacteriol. Rev. 1967, 31, 373–403. [Google Scholar] [CrossRef] [PubMed]
- Kieser, T.; Bibb, M.J.; Buttner, M.J.; Chater, K.F.; Hopwood, D.A. Practical Streptomyces Genetics; Innes: Norwich, England, 2000. [Google Scholar]
- Beever, R.E.; Bollard, E.G. The nature of the stimulation of fungal growth by potato extract. Microbiology 1970, 60, 273–279. [Google Scholar] [CrossRef]
- Mehnert, M.; Retamal-Morales, G.; Schwabe, R.; Vater, S.; Heine, T.; Levicán, G.J.; Schlömann, M.; Tischler, D. Revisiting the Chrome Azurol S assay for various metal ions. Solid State Phenom. 2017, 262, 509–512. [Google Scholar] [CrossRef]
- Rungin, S.; Indananda, C.; Suttiviriya, P.; Kruasuwan, W.; Jaemsaeng, R.; Thamchaipenet, A. Plant growth enhancing effects by a siderophore–producing endophytic streptomycete isolated from a Thai jasmine rice plant (Oryza sativa L. Cv. KDML105). Antonie Van Leeuwenhoek 2012, 102, 463–472. [Google Scholar] [CrossRef] [PubMed]
- Gangwar, M.; Rani, S.; Sharma, N. Diversity of endophytic actinomycetes from wheat and its potential as plant growth promoting and biocontrol agents. J. Adv. Lab. Res. Biol. 2012, 3, 13–19. [Google Scholar]
- Gordon, S.A.; Weber, R.P. Colorimetric estimation of indoleacetic acid. Plant Physiol. 1951, 26, 192–195. [Google Scholar] [CrossRef] [PubMed]
- Yarza, P.; Yilmaz, P.; Pruesse, E.; Glöckner, F.O.; Ludwig, W.; Schleifer, K.-H.; Whitman, W.B.; Euzéby, J.; Amann, R.; Rosselló-Móra, R. Uniting the classification of cultured and uncultured bacteria and archaea using 16S rRNA gene sequences. Nat. Rev. Microbiol. 2014, 12, 635–645. [Google Scholar] [CrossRef]
- Glaeser, S.P.; Kämpfer, P. Multilocus sequence analysis (MLSA) in prokaryotic taxonomy. Syst. Appl. Microbiol. 2015, 38, 237–245. [Google Scholar] [CrossRef]
- Ferraz Helene, C.L.; Klepa, M.S.; Hungria, M. New insights into the taxonomy of bacteria in the genomic era and a case study with rhizobia. Int. J. Microbiol. 2022, 2022, 4623713. [Google Scholar] [CrossRef]
- Nei, M.; Kumar, S. Molecular Evolution and Phylogenetics; Oxford University Press: New York, NY, USA, 2000. [Google Scholar]
- Carro, L.; Golinska, P.; Nouioui, I.; Bull, A.T.; Igual, J.M.; Andrews, B.A.; Klenk, H.P.; Goodfellow, M. Micromonospora acroterricola sp. nov., a novel actinobacterium isolated from a high altitude Atacama Desert soil. Int. J. Syst. Evol. Microbiol. 2019, 69, 3426–3436. [Google Scholar] [CrossRef] [PubMed]
- El-Tarabily, K.A.; Nassar, A.H.; Hardy, G.E.; Sivasithamparam, K. Plant growth promotion and biological control of Pythium aphanidermatum, a pathogen of cucumber, by endophytic actinomycetes. J. Appl. Microbiol. 2009, 106, 13–26. [Google Scholar] [CrossRef] [PubMed]
- Talukdar, M.; Duarah, A.; Talukdar, S.; Gohain, M.B.; Debnath, R.; Yadav, A.; Jha, D.K.; Bora, T.C. Bioprospecting Micromonospora from Kaziranga National Park of India and their anti–infective potential. World J. Microbiol. Biotechnol. 2012, 28, 2703–2712. [Google Scholar] [CrossRef] [PubMed]
- Igarashi, Y.; Matsuyuki, Y.; Yamada, M.; Fujihara, N.; Harunari, E.; Oku, N.; Karim, M.R.U.; Yang, T.; Yamada, K.; Imada, C.; et al. Structure determination, biosynthetic origin, and total synthesis of akazaoxime, an enteromycin–class metabolite from a marine–derived actinomycete of the genus Micromonospora. J. Org. Chem. 2021, 86, 6528–6537. [Google Scholar] [CrossRef] [PubMed]
- Amin, D.H.; Abolmaaty, A.; Tolba, S.; Abdallah, N.A.; Wellington, E.M.H. Phylogenic characteristics of a unique antagonistic Micromonospora sp. Rc5 to S. aureus isolated from Sinai Desert of Egypt. Annu. Res. Rev. Biol. 2018, 22, 1–15. [Google Scholar] [CrossRef]
- Sineva, O.N.; Bychkova, O.P.; Terekhova, L.P. Acidotolerant actinomycetes of the genus Micromonospora are producers of antibiotic compounds. In Proceedings of the First International Electronic Conference on Antibiotics, Online, 8–17 May 2021. [Google Scholar]
- Martínez–Hidalgo, P.; García, J.M.; Pozo, M.J. Induced systemic resistance against Botrytis cinerea by Micromonospora strains isolated from root nodules. Front. Microbiol. 2015, 6, 145475. [Google Scholar] [CrossRef] [PubMed]
- Mark, D.; DeWald, J.; Dorador, C.; Tucker, N.; Herron, P. Characterisation of anti–pseudomonad activity of hyper–arid Micromonospora species. Access Microbiol. 2023, 2, 7A. [Google Scholar] [CrossRef]
- Ortúzar, M.; Trujillo, M.E.; Román-Ponce, B.; Carro, L. Micromonospora metallophores: A plant growth promotion trait useful for bacterial–assisted phytoremediation? Sci. Total Environ. 2020, 739, 139850. [Google Scholar] [CrossRef] [PubMed]
- Yang, X.; Zhu, Z.-H.; Ji, X.; Liu, Z.-M.; Zhang, H.; Wei, B. Complete genome sequence of Micromonospora craniellae LHW63014T, a potential metal ion–chelating agent producer. Mar. Genom. 2021, 57, 100830. [Google Scholar] [CrossRef]
- Glick, B.R. Introduction to plant growth–promoting bacteria. In Beneficial Plant-Bacterial Interactions; Glick, B.R., Ed.; Springer International Publishing: Cham, Switzerland, 2020; pp. 1–37. [Google Scholar]
- Goswami, D.; Thakker, J.N.; Dhandhukia, P.C. Simultaneous detection and quantification of indole-3-acetic acid (IAA) and indole-3-butyric acid (IBA) produced by rhizobacteria from L–tryptophan (Trp) using HPTLC. J. Microbiol. Methods. 2015, 110, 7–14. [Google Scholar] [CrossRef]
- Shutsrirung, A.; Chromkaew, Y.; Pathom-Aree, W.; Choonluchanon, S.; Boonkerd, N. Diversity of endophytic actinomycetes in mandarin grown in northern Thailand, their phytohormone production potential and plant growth promoting activity. Soil Sci. Plant Nutr. 2013, 59, 322–330. [Google Scholar] [CrossRef]
- Martínez–Hidalgo, P.; Galindo-Villardón, P.; Trujillo, M.E.; Igual, J.M.; Martínez-Molina, E. Micromonospora from nitrogen fixing nodules of alfalfa (Medicago sativa L.). a new promising plant probiotic bacteria. Sci. Rep. 2014, 4, 6389. [Google Scholar] [CrossRef] [PubMed]
- Della Mónica, I.F.; Novas, M.V.; Iannone, L.J.; Querejeta, G.; Scervino, J.M.; Pitta-Alvarez, S.I.; Regalado, J.J. Infection with Micromonospora strain SB3 promotes in vitro growth of Lolium multiflorum plantlets. Plant Cell Tissue Organ Cult. 2018, 134, 445–455. [Google Scholar] [CrossRef]
- Tamura, K.; Nei, M. Estimation of the number of nucleotide substitutions in the control region of mitochondrial DNA in humans and chimpanzees. Mol. Biol. Evol. 1993, 10, 512–526. [Google Scholar]

Disclaimer/Publisher’s Note: The statements, opinions and data contained in all publications are solely those of the individual author(s) and contributor(s) and not of MDPI and/or the editor(s). MDPI and/or the editor(s) disclaim responsibility for any injury to people or property resulting from any ideas, methods, instructions or products referred to in the content. |
© 2024 by the authors. Licensee MDPI, Basel, Switzerland. This article is an open access article distributed under the terms and conditions of the Creative Commons Attribution (CC BY) license (https://creativecommons.org/licenses/by/4.0/).
Share and Cite
Sokołowski, W.; Wdowiak-Wróbel, S.; Marek-Kozaczuk, M.; Kalita, M. In Vitro Screening of Endophytic Micromonospora Strains Associated with White Clover for Antimicrobial Activity against Phytopathogenic Fungi and Promotion of Plant Growth. Agronomy 2024, 14, 1062. https://doi.org/10.3390/agronomy14051062
Sokołowski W, Wdowiak-Wróbel S, Marek-Kozaczuk M, Kalita M. In Vitro Screening of Endophytic Micromonospora Strains Associated with White Clover for Antimicrobial Activity against Phytopathogenic Fungi and Promotion of Plant Growth. Agronomy. 2024; 14(5):1062. https://doi.org/10.3390/agronomy14051062
Chicago/Turabian StyleSokołowski, Wojciech, Sylwia Wdowiak-Wróbel, Monika Marek-Kozaczuk, and Michał Kalita. 2024. "In Vitro Screening of Endophytic Micromonospora Strains Associated with White Clover for Antimicrobial Activity against Phytopathogenic Fungi and Promotion of Plant Growth" Agronomy 14, no. 5: 1062. https://doi.org/10.3390/agronomy14051062
APA StyleSokołowski, W., Wdowiak-Wróbel, S., Marek-Kozaczuk, M., & Kalita, M. (2024). In Vitro Screening of Endophytic Micromonospora Strains Associated with White Clover for Antimicrobial Activity against Phytopathogenic Fungi and Promotion of Plant Growth. Agronomy, 14(5), 1062. https://doi.org/10.3390/agronomy14051062





